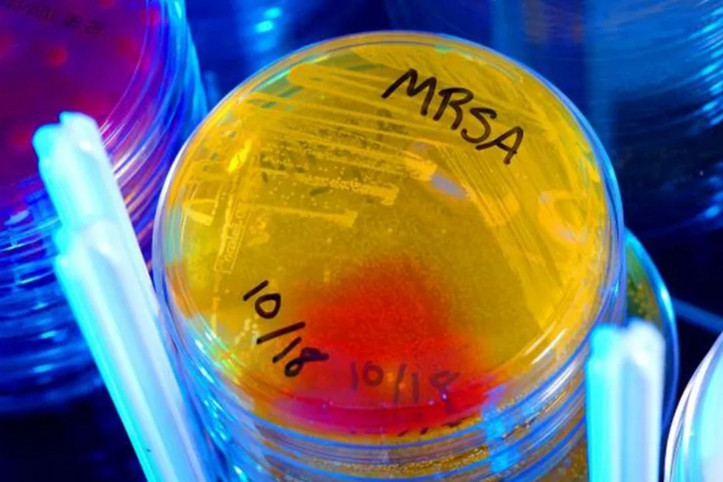
Tıp dünyasını heyecanlandıran 'tesadüfi' keşif: Dirençli bakterilere karşı 100 kat daha etkili

Dolar
Dolar
42,53
Euro
Euro
49,63
Gram Altın
G. Altın
5.776,65
Bitcoin
Btc
92.161
Dolar
Dolar
42,53
Euro
Euro
49,63
Gram Altın
G. Altın
5.776,65
Bitcoin
Btc
92.161



